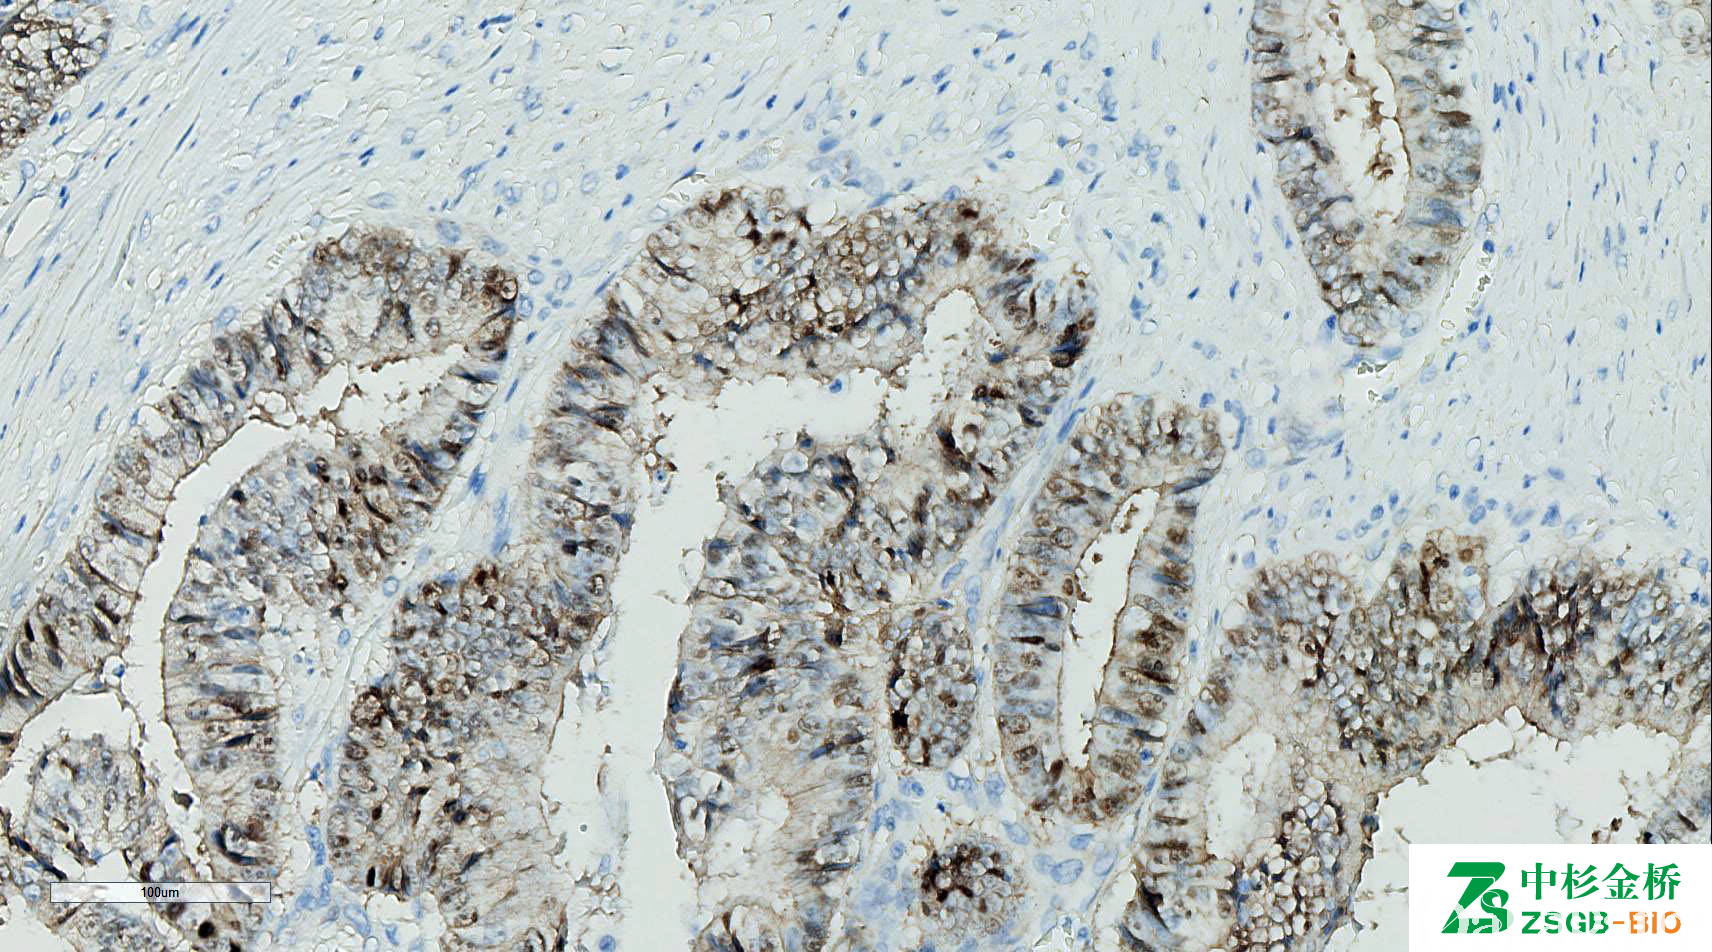

β-catenin
别名: β-catenin
概述:
WNT 信号通路的重要调节蛋白。在静止细胞中与 E-Cadherin 的胞内部分结合,以稳定细胞间黏附;在 WNT 信号激活的细胞中由胞浆进入胞核成为转录激活因子。
信号定位: 胞质、胞核
在病理学中的应用:
1、肝细胞腺瘤亚型分类和区分局灶性结节性增生;
2、鉴别肠系膜纤维瘤病(+)与 GIST(-)和硬化型肠系膜炎(-);
3、鉴别纤维瘤病(弥漫+,深部肿瘤局灶+)和低度恶性纤维黏液样肉瘤、其他肌纤维母细胞和纤维母细胞肿瘤(核-);
4、识别神经母细胞瘤中孤立的肿瘤细胞;
5、鼻咽癌的预后不良因素;
6、其自身发生突变或与之结合的 APC 蛋白异常时,可 出现异常核表达,见于部分大肠癌、胰腺实性假乳头性肿瘤、深部软组织纤维瘤(韧带样型)、鼻咽血管纤维瘤。
商品化试剂(排名不分先后,本网站对抗体质量不负责!)
公司 | 克隆号 | 即用型(ml) | 原液(ml) | ||||
基因科技 | E247 | 2 | 4 | 7 | / | 0.2 | 1 |
赛诺特 | 17C2 | 1 | 3 | 6 | / | 0.1 | 0.2 |
14 | 1 | 3 | 6 | / | 0.1 | 0.2 | |
中杉金桥 | UMAB15 | 1.5 | 3 | 6 | / | 0.1 | 0.2 |
EP35 | |||||||
安必平 | 14 | 1.5 | 3 | 6 | / | 0.1 | 0.2 |
福建迈新 | CAT-5H10 | 1.5 | 3 | 6 | / | / | 0.2 |
基因科技 | E247 | 1 | 2 | 4 | 7 | / | 0.2 |